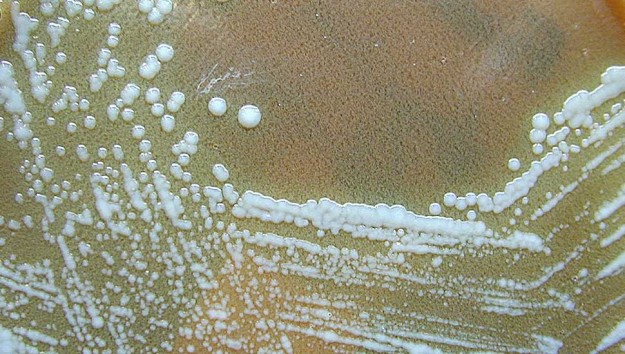
francisella

Advances in antioxidants
Authors: Andrej Ovca, Borut Poljšak Type of paper: Review Issue: Volume 2 | number 2 – 2008 Photo: matanzaschiro.com Abstract: Tokratni mednarodni kongres (že peti po vrsti), katerega rdeča nit je bil napredek raziskav na področju antioksidantov je potekal v Tuniziji (Monastir – Sousse) od 11. do 15. oktobra 2008. V programu so bile zajete vse tri…